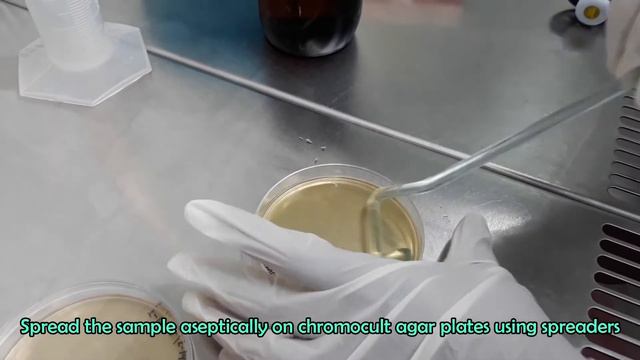
Enumeration of Escherichia coli (Total E. coli Count)_A Complete Procedure (ISO 9308-1 & ISO 16649) смотреть онлайн

Автор / Канал: Знания и любовь к искусству Страница 14

Век живи - век учись! A motivational interview with our 86-year old Russian language student Rosa

Конфликт интересов 11.06.17

Если ты это не узнаешь, ты проживаешь свою жизнь зря - Честь Teil 5

Оксана Духовная 17 07 2017

Bb Major Play Along (Tonic, Subdominant, and Dominant) - 2 measures

Борис Увайдов. Наука исцеления пиявками.

Mesto - Don't Worry (Lyrics) ft. Aloe Blacc

Tafseer-e-Quran Class #374 (Surah Taha Rukoo 02) | Mufti Tariq Masood Speeches 🕋

Что делать с молодым лимоном после покупки. #лимоны #цитрусовые

А.В.Чайковский Концерт-буфф для скрипки и маримбы с оркестром (1996) 4 часть

Удар Виталя Факинеля, занесенный в книгу рекордов Гиннеса

COUCHER vs DORMIR. КАКОЙ ГЛАГОЛ УПОТРЕБИТЬ | Урок французского языка | Французские глаголы.

21st May 2020 | Introdution to IOT | Ramalingam govindaraj | lets talk lets connect

"Как много в мире есть дорог широких" - Дети

Щука в Старый Новый Год! 13 января 2024 г.

Знакомство с сообществом West Hub

LAZADA HAUL | 5.5 SALE | AFFORDABLE FINDS 2021 | Eva Ronda

live together, die alone; secrets (03.12.16) (2/2)

Fallout New Vegas All Wild Wasteland Encounters

Полная попа!

Любимая дочь Анастасия... С Любовью и Благодарностью!

ДЕНЬ РОЖДЕНИЯ ДЯДИ ВОВЫ. RJABINOVAYA GARAGE
Enumeration of Escherichia coli (Total E. coli Count)_A Complete Procedure (ISO 9308-1 & ISO 16649)

СНЕГ ЗИМОЙ И РАДОСТЬ В КАЖДОМ ДНЕ!
За каждым успешным каналом стоит личность, идея и сотни часов кропотливого труда. Если вы здесь, значит, автор «Знания и любовь к искусству» уже сумел зацепить ваше внимание своим уникальным стилем или подачей. А мы на RUVIDEO позаботились о том, чтобы вы могли изучить весь архив его работ в максимально комфортных условиях — без лишней суеты и преград.
Почему за работами канала «Знания и любовь к искусству» так интересно наблюдать? Всё просто: это честный контент, который находит отклик в сердцах зрителей. На нашем ресурсе вы можете смотреть онлайн все видео любимого автора бесплатно и в хорошем качестве. Нам важно, чтобы вы видели каждую деталь и слышали каждый нюанс, поэтому мы используем только стабильные плееры из открытых источников Rutube.
Следите за новинками канала, пересматривайте старые шедевры и открывайте для себя новые грани творчества «Знания и любовь к искусству». Мы постоянно обновляем ленту, чтобы у вас под рукой всегда были самые свежие выпуски. Никаких сложных регистраций — только вы и творчество, которое вдохновляет. Приятного вам путешествия по миру авторского контента на RUVIDEO!
Видео взято из открытых источников Rutube. Если вы правообладатель, обратитесь к первоисточнику.